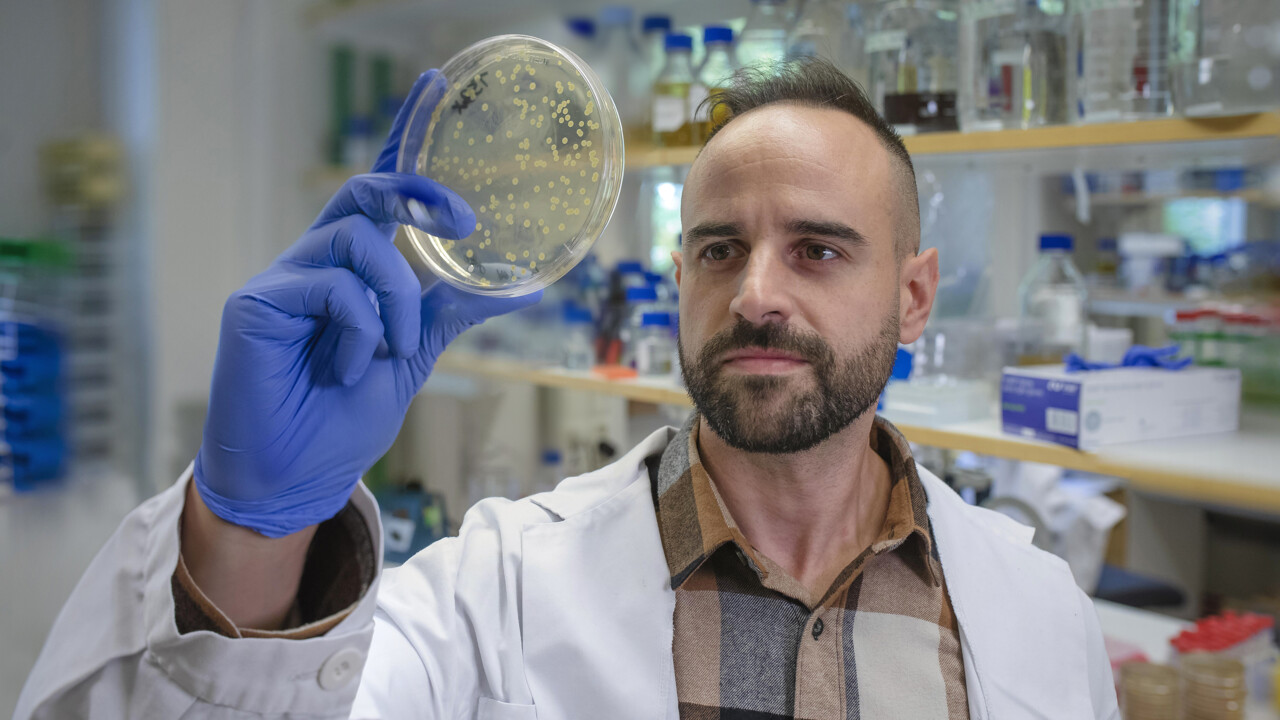
Gabriel Torrens Gabriel Torrens Gabriel Torrens Gabriel Torrens

Korta fakta om Gabriel
Bor: I Umeå och kommer från Mallorca
Jag med tre ord: Envis, kreativ, självständig
Intressen: Mikrobiologi, idrott, astronomi, psykologi, filosofi och resor
Fascinerande fakta om mikrobiologi: Bakteriers extraordinära förmåga att anpassa sig till fientliga miljöer
Läser: Allt från fantasy- och historieböcker till samhällsfilosofi
Lyssnar på: Rock, elektronisk och alternativ musik
Oväntad talang: Är en fena på att fotografera
Saknar hemifrån: ”Tombet” – en traditionell grönsaksrätt från Mallorca
Det första svenska ordet jag lärde mig: Fika!
Drömde om att bli när jag var liten: Funderade på många yrken men alltid att det skulle vara relaterat till vetenskap